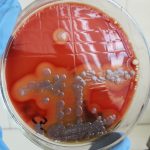
Какие инфекции показывает бак посев

Нет, наверное, человека, который не знал бы, как выглядит подорожник, ведь это растение из нашего детства. Кто из детей придавал большое значение мелкой ссадине или разбитой коленке? Кто бежал домой, чтобы ранку замазали зеленкой? Вот еще, ведь столько интересного пропустишь! А потому на бегу срывали прохладный листик подорожника, немного...                    
                    
                
                        Высокая ценность отвара из ячменя обусловлена использованием для его приготовления цельного неочищенного зерна. Оболочка семени содержит большое количество полезных веществ, которые полностью переходят в настой и оказывают лечебное воздействие на организм. Чем же ценен отвар из ячменя? Он содержитправильные пропорции белка (15%), имеющего высокую пищевую ценность, и углеводов (73%);большое...                    
                    
                ЭТО ВАМ ПРИГОДИТСЯ
Показания к магнитно-резонансной томографии
                    
Магнитно-резонансная томография в Уфе — это высокоинформативный метод диагностики, который позволяет получать подробные изображения внутренних органов, тканей и систем организма. Показания к проведению МРТ...                
            Спортивная фармакология — что выбрать ??
                     Применение спортивной фармакологии в бодибилдинге обусловлено многими факторами, которые заключаются в поддержке организма спортсмена в период тяжелых тренировок и так называемые моменты застоя...                
            Комфортная перевозка лежачих больных от профессионалов своего дела
                    Транспортировка пациентов в Харькове https://format.org.ua/kharkov/, которые страдают серьезными заболеваниями, это одна из разновидностей оказания медицинской помощи. Перемещение больного в машине скорой помощи проводится только...                
            Прием на работу иностранных граждан в 2021 году
                    
На сегодняшний день российские организации имеют право принимать на работу иностранных граждан, однако при этом крайне важно соблюдать определенные правила, установленные Законодательством. Нарушение закона...                
            Какие инфекции показывает бак посев
                    
В мире, невидимом для невооруженного глаза, развертывается настоящая драма в микроскопических масштабах, где героями являются бактерии. И чтобы раскрыть этот биологический триллер, на помощь...                
            Ремонт мотоблока Бригадир: основные поломки и их устранение
                    Мотоблок является техническим средством, предназначенным для оперативного выполнения различных видов работ, связанных с землей.
Данное приспособление используется для отвоза продуктов с полей, покоса травы и...                
            
		
		
А на вашем подоконнике есть… своя аптека? Если да, то вы уже успели оценить неоценимую пользу, которую приносят здоровью растения-целители: алоэ, каланхое, золотой ус и многие другие. Если нет, то самое время задуматься о том, что никакие искусственные средства лечения и (особенно) профилактики не могут сравниться с естественным и безопасным методом лечения травами.